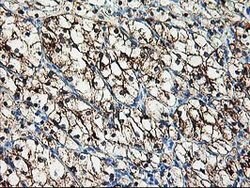
AK4 Mouse anti-Human, Clone: OTI2D1, lyophilized, TrueMAB 100 &mu;g | Buy Online | Origene Technologies | Fisher Scientific

missing translation for 'onlineSavingsMsg'
Learn More
Learn More
AK4 Mouse anti-Human, Clone: OTI2D1, lyophilized, TrueMAB™

Description
Reconstitute with PBS (pH 7.3) and recommend to perform another round of desalting process using Product No. 7KMWCO
This gene encodes a member of the adenylate kinase family of enzymes. The encoded protein is localized to the mitochondrial matrix. Adenylate kinases regulate the adenine and guanine nucleotide compositions within a cell by catalyzing the reversible transfer of phosphate group among these nucleotides. Five isozymes of adenylate kinase have been identified in vertebrates. Expression of these isozymes is tissue-specific and developmentally regulated. A pseudogene for this gene has been located on chromosome 17. Three transcript variants encoding the same protein have been identified for this gene. Sequence alignment suggests that the gene defined by NM_013410, NM_203464, and NM_001005353 is located on chromosome 1.
Specifications
Specifications
| Antigen | AK4 |
| Applications | Flow Cytometry, Immunocytochemistry, Immunofluorescence, Immunohistochemistry (Paraffin), Western Blot |
| Classification | Monoclonal |
| Clone | OTI2D1 |
| Conjugate | Unconjugated |
| Formulation | PBS with 8% trehalose and no preservative; pH 7.3 |
| Gene | AK4 |
| Gene Accession No. | P27144 |
| Gene Alias | AK 4, AK3, AK3L1, AK3L2 |
| Gene Symbols | AK4 |
| Show More |
Product Title
By clicking Submit, you acknowledge that you may be contacted by Fisher Scientific in regards to the feedback you have provided in this form. We will not share your information for any other purposes. All contact information provided shall also be maintained in accordance with our Privacy Policy.
Spot an opportunity for improvement?